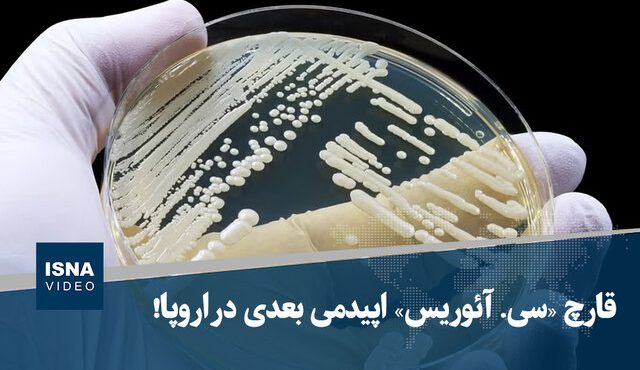

هشداری برای بیمارستانها؛ قارچ سی. آئوریس میتواند اپیدمی بعدی اروپا باشد
گزارشهای اخیر نشان میدهد Candida auris، قارچی که بهسرعت در محیطهای بیمارستانی گسترش یافته و در بسیاری از … ادامه خواندن هشداری برای بیمارستانها؛ قارچ سی. آئوریس میتواند اپیدمی بعدی اروپا باشد